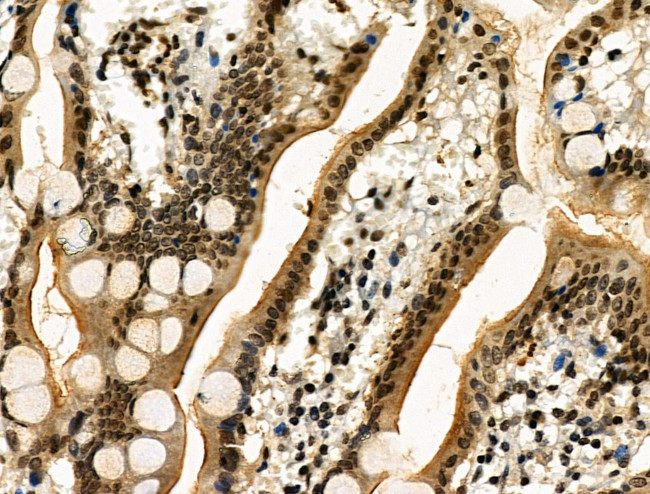
Phospho-RAD17 (Ser646) Antibody in Immunohistochemistry (Paraffin) (IHC (P))

Search
Invitrogen
Phospho-RAD17 (Ser646) Polyclonal Antibody
{{$productOrderCtrl.translations['antibody.pdp.commerceCard.promotion.promotions']}}
{{$productOrderCtrl.translations['antibody.pdp.commerceCard.promotion.viewpromo']}}
{{$productOrderCtrl.translations['antibody.pdp.commerceCard.promotion.promocode']}}: {{promo.promoCode}} {{promo.promoTitle}} {{promo.promoDescription}}. {{$productOrderCtrl.translations['antibody.pdp.commerceCard.promotion.learnmore']}}
图: 1 / 9
Phospho-RAD17 (Ser646) Antibody (PA5-106030) in IHC (P)









产品信息
PA5-106030
种属反应
宿主/亚型
分类
类型
抗原
偶联物
形式
浓度
规格
纯化类型
保存液
内含物
保存条件
运输条件
RRID
产品详细信息
Antibody detects endogenous levels of RAD17 only when phosphorylated at Ser646.
靶标信息
Rad17 is essential for sustained cell growth, maintenance of chromosomal stability, and ATR-dependent checkpoint activation upon DNA damage. It has a weak ATPase activity required for binding to chromatin. Rad17 also participates in the recruitment of the RAD1-RAD9-HUS1 complex and RHNO1 onto chromatin, and in CHEK1 activation. May also serve as a sensor of DNA replication progression, and may be involved in homologous recombination.
仅用于科研。不用于诊断过程。未经明确授权不得转售。
篇参考文献 (0)
生物信息学
蛋白别名: cell cycle checkpoint protein (RAD17); Cell cycle checkpoint protein RAD17; FLJ41520; hRad17; RAD1 homolog; RAD17 (Ser647); RAD17 homolog; Rad17 like protein; Rad17-like protein; RF-C activator 1 homolog; RF-C/activator 1 homolog; similar to checkpoint protein; unnamed protein product
基因别名: CCYC; HRAD17; MmRad24; R24L; RAD17; RAD17SP; RAD24
UniProt ID: (Human) O75943, (Mouse) Q6NXW6
Entrez Gene ID: (Human) 5884, (Rat) 310034, (Mouse) 19356